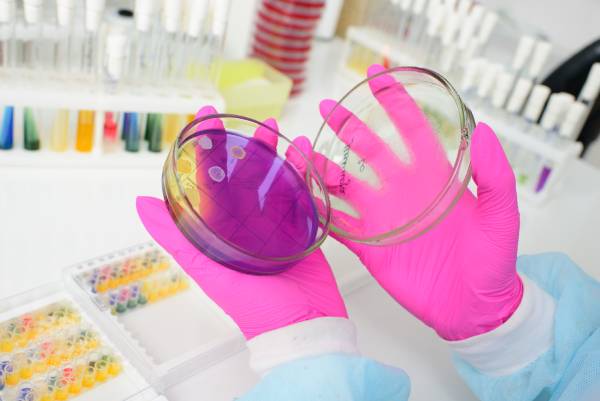

VÝROBA BIOLOGICKÝCH INDIKÁTORŮ
Odpovědná osoba: Ing. Zdeňka Pelešková zdenka.peleskova@zuusti.cz +420 371 408 205
Adresa pracoviště: 17. listopadu 1, 301 00 Plzeň
Objednávka služeb: +420 371 408 304 plz.bio@zuusti.cz
Výroba, prodej a distribuce biologických indikátorů pro kontrolu účinnosti sterilizační techniky.
Připravujeme bioindikátory pro kontrolu účinnosti sterilizační techniky. Biologický indikátor je naočkovaný nosič zkušebním organismem Bacillus atrophaeus CCM 4624 nebo Geobacillus stearothermophilus CCM 4395 v primárním obalu připravený přímo k použití.
Ročně jsou vyráběny a expedovány čtyři šarže, vždy pro příslušné čtvrtletí.
Oddělení je držitelem certifikátu ČSN EN ISO 9001.
DRUHY NABÍZENÝCH BIOLOGICKÝCH INDIKÁTORŮ:
- Geobacillus stearothermophilus pro sterilizaci vlhkým teplem a formaldehydem
- Geobacillus stearothermophilus pro plazmovou sterilizaci
- Bacillus atrophaeus pro sterilizaci ethylenoxidem
- Bacillus atrophaeus pro sterilizaci suchým teplem (horkovzdušná sterilizace)
DALŠÍ INFORMACE
Objednávka služeb – všeobecná
Systém kvality
KULTIVAČNÍ MÉDIA
Informace poskytované výrobcem – kultivační půdy
Návod k použití – testovací organismy pro kontrolu kvality kultivačních médií
Informace poskytované výrobcem – reagencie/chemikálie pro laboratorní použití a IVD
Návod k použití – reagencie/chemikálie pro laboratorní použití a IVD
Prohlížení bezpečnostních listů, kontroly kvality, transportních podmínek a certifikace
Systém kvality